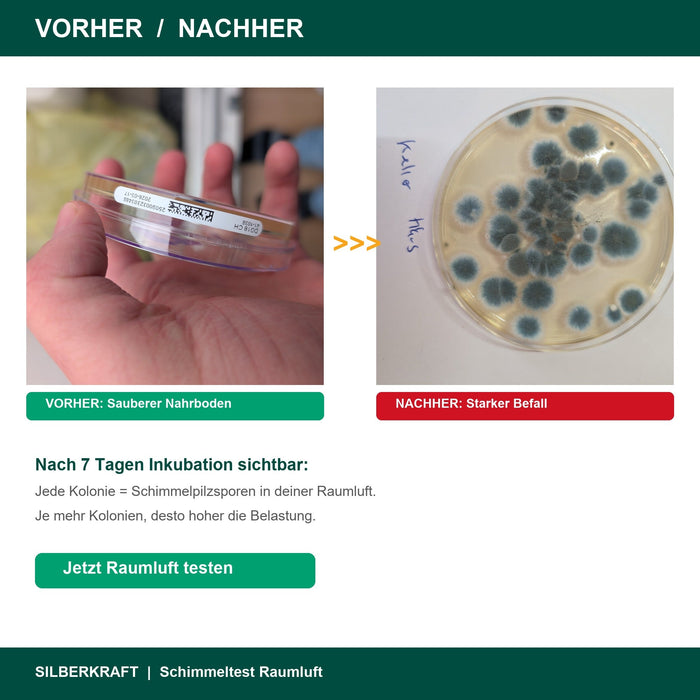
Schimmeltest Vorher Nachher - Saubere vs befallene Petrischale
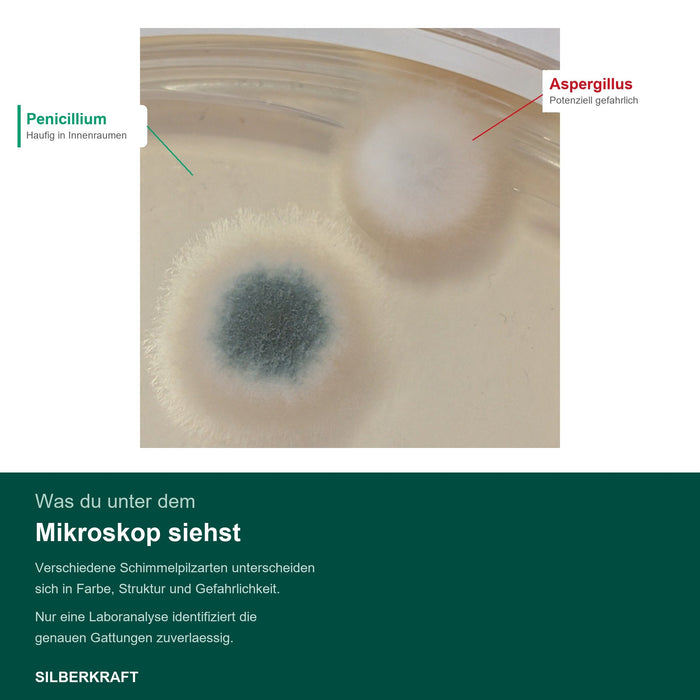
Schimmelpilz-Kolonien Detailaufnahme unter dem Mikroskop
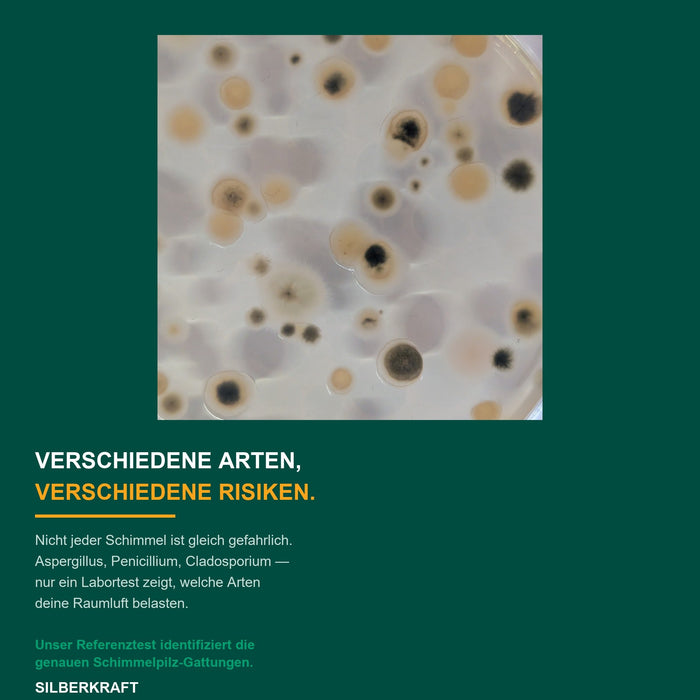
Verschiedene Schimmelpilzarten verschiedene Risiken

Dein Weg zu mehr Wohngesundheit: Den richtigen Schimmeltest für deine Situation finden
Die Suche nach "Schimmeltest" oder "Schimmel in der Wohnung" ist der erste Schritt, um die Kontrolle über deine Wohngesundheit zurückzugewinnen. Doch welcher Test ist der richtige für dich? Bei Silberkraft verstehen wir, dass jede Situation anders ist. Deshalb bieten wir dir zwei Wege zur Klarheit: den schnellen Selbsttest für eine erste Einschätzung und das professionelle Labor-Komplett-Set für eine tiefgehende, wissenschaftliche Analyse.Wann ist ein Selbsttest sinnvoll?
Ein Schimmel-Selbsttest für zuhause ist ein hervorragender erster Schritt. Er gibt dir schnell und kostengünstig eine erste Indikation, ob eine erhöhte Schimmelpilzkonzentration in einem Raum vorliegt. Er ist ideal, wenn du einen vagen Verdacht hast und eine schnelle Tendenz benötigst, ohne sofort eine vollständige Analyse durchführen zu wollen.Der entscheidende nächste Schritt: Die Laboranalyse für Klarheit und Handlungssicherheit
Während ein Selbsttest "ob" anzeigt, beantwortet unser Schimmeltest Komplett-Set mit Laboranalyse die wirklich entscheidenden Fragen:
- WELCHE Schimmelart wächst hier? (z.B. harmlos oder potenziell gesundheitsgefährdend?)
- WIE HOCH ist die Konzentration der Sporen in der Luft? (Ist die Belastung gering oder alarmierend?)
- WAS SIND die wahrscheinlichsten Ursachen und WAS TUE ICH JETZT?
Genau hier liegt der Mehrwert unseres Labor-Sets: Wir liefern dir nicht nur ein Ergebnis. Wir liefern dir einen vollständigen Lösungsansatz. Der detaillierte Bericht analysiert die Schimmelgattung, bewertet das Gesundheitsrisiko und gibt dir, zusammen mit unserem Experten-E-Book, konkrete Maßnahmen an die Hand. Wir helfen dir, das Problem an der Wurzel zu packen und es selbst zu beseitigen.Ein Komplett-Set, das sowohl die unsichtbare Raumluft als auch sichtbaren Befall an Oberflächen (Wand, Fugen) untersucht, bietet dir maximale Sicherheit. Es ist die perfekte Grundlage für eine gezielte Schimmelbeseitigung und dein wichtigstes Dokument gegenüber Vermietern oder bei einem Immobilienkauf. Investiere in Wissen und Kontrolle – für ein nachweislich gesundes Zuhause.